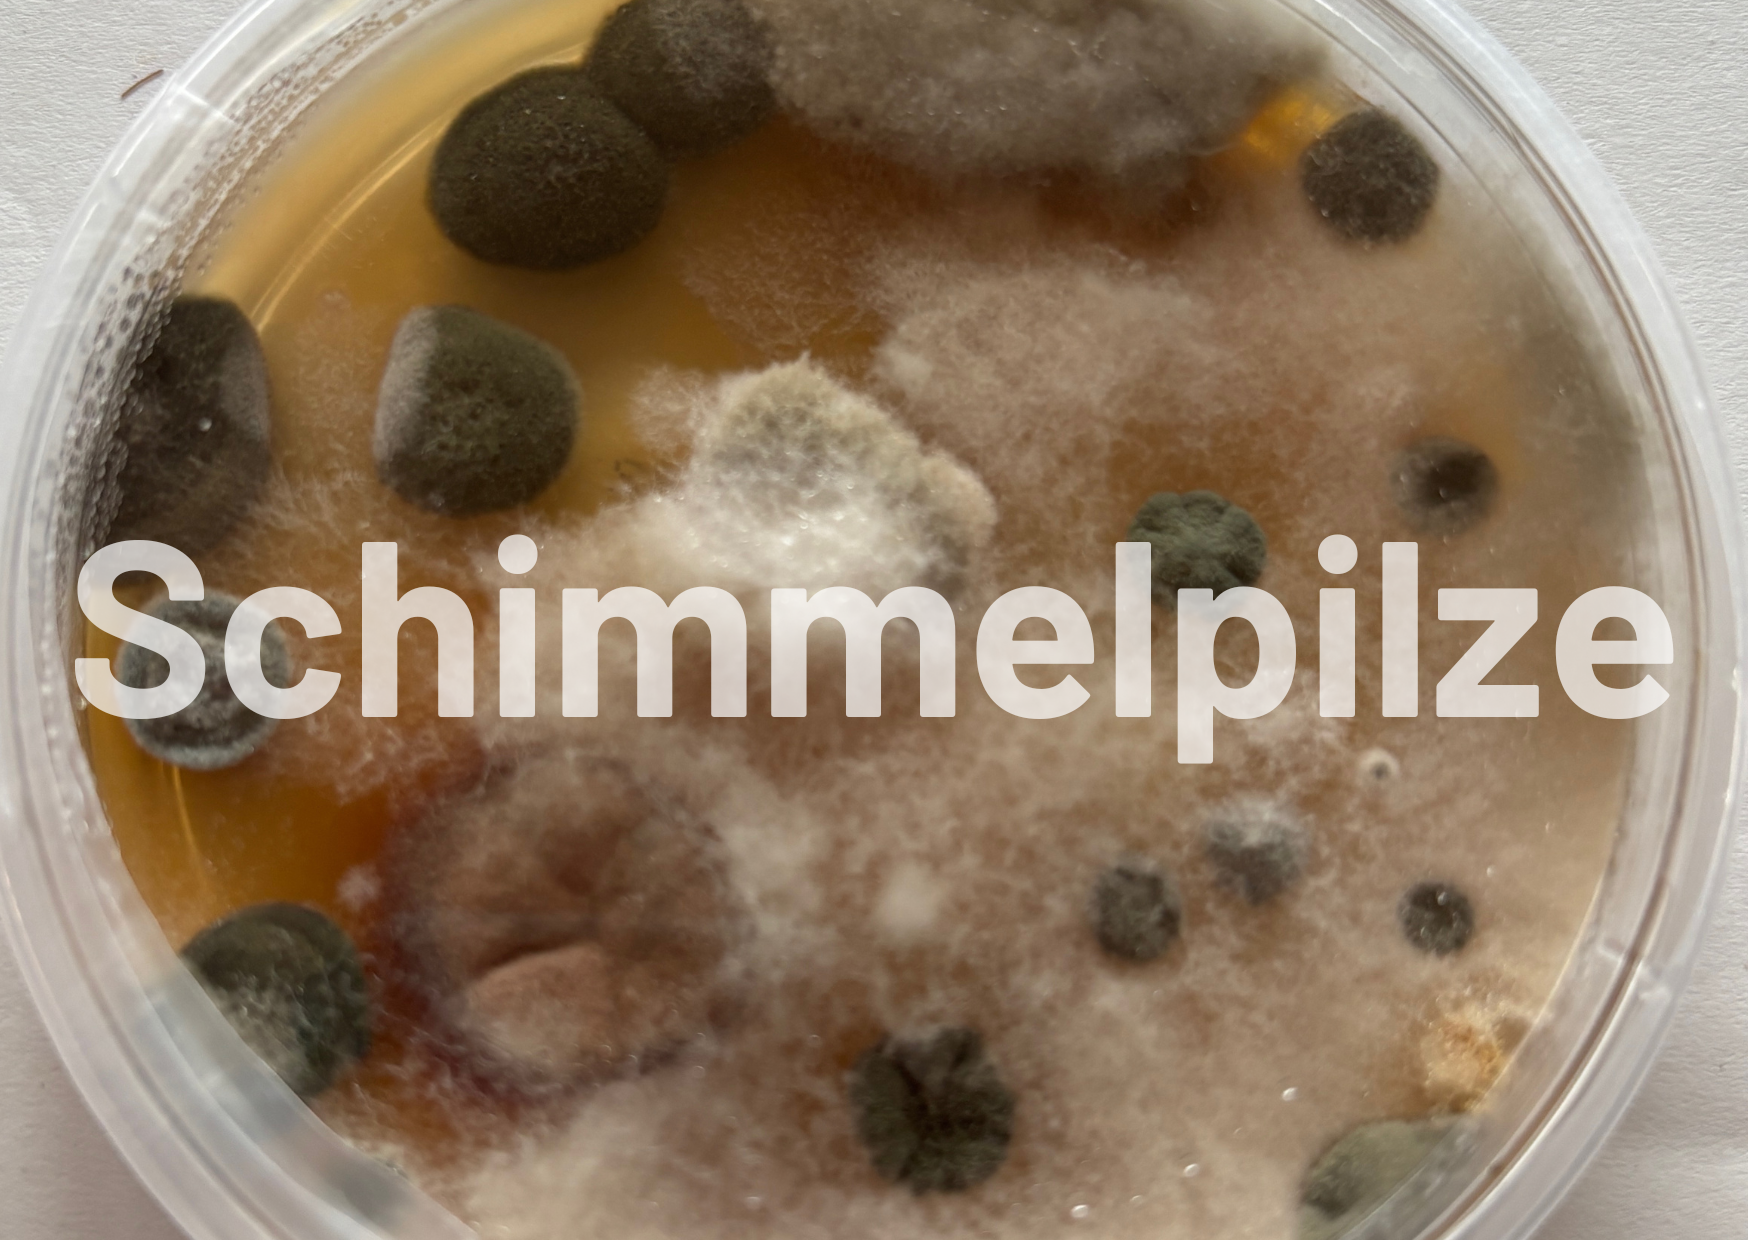
Schimmelpilze in Innenräumen sind gesundheitsgefährdend

Jede:r kennt Schimmel. Viele zum Glück nur vom alten Brot, andere leider von den eigenen Wänden, Fensterlaibungen oder der Dusche. Schimmel in der Wohnung ist nicht nur ein optisches Problem. Er kann deine Gesundheit belasten und zeigt gleichzeitig, dass mit Feuchtigkeit, Bauphysik oder Wohnverhalten etwas nicht stimmt.
Was ist Schimmel?
Wenn wir von Schimmel sprechen, meinen wir in der Regel Schimmelpilze. Das eine Gruppe von Pilzen, die fädige Strukturen (Hyphen) und ein Geflecht, das sogenannte Myzel, bilden. Das, was du als pelzigen Belag oder Fleck siehst, ist nur der sichtbare Teil des Pilzes. Der Großteil spielt sich im Untergrund und im Material selbst ab.
In der Natur sind Schimmelpilze enorm wichtig: Sie bauen abgestorbene Pflanzen, Holz und andere organische Materialien ab und sorgen dafür, dass Nährstoffe wieder in den Kreislauf zurückkehren. Deshalb sind Schimmelpilzsporen überall in der Luft nachweisbar, auch in deiner Wohnung. Solange die Sporenkonzentration im normalen Bereich bleibt und dein Immunsystem stabil ist, ist das kein Problem. Kritisch wird es, wenn Schimmelpilze in Innenräumen aktiv wachsen, also ein sichtbarer oder verborgener Befall entsteht. Dann steigen die Sporenkonzentrationen deutlich an, und es kommen Stoffwechselprodukte wie Mykotoxine und geruchlich wahrnehmbare MVOC dazu.
Wie gefährlich ist Schimmel?
Bei einem gesunden Immunsystem und normaler natürlicher Schimmelpilzsporenbelastung sind in der Regel keine akuten Gesundheitsrisiken zu erwarten. Problematisch wird es, wenn in Innenräumen durch einen Befall die Sporenmenge um ein Vielfaches steigt.
Typische Beschwerden bei längerem Aufenthalt in schimmelbelasteten Räumen können sein:
- dauernder oder wiederkehrender Schnupfen,
- Husten, Reizhusten, Atemwegserkrankungen,
- Kopfschmerzen, Schlafstörungen, Müdigkeit,
- brennende, juckende oder tränende Augen,
- Hautprobleme wie Neurodermitis,
- Allergien und allergisches Asthma,
- erhöhte Infektanfälligkeit.
Schimmelpilze und ihre Sporen können:
- allergische Reaktionen und asthmatische Beschwerden auslösen,
- reizende Stoffe (MVOC) freisetzen, die für den typischen muffigen Geruch sorgen,
- Mykotoxine (Pilzgifte) bilden, die auch in geringen Mengen bei dauerhafter Belastung relevant sein können,
- bei immungeschwächten Menschen sogar im Körper wachsen und schwere Infektionen verursachen.
Schimmelpilze gehören nicht zur normalen Flora des Menschen. Aber ein gesunder Körper kann einzelne Sporen in der Regel gut bewältigen. Das Risiko entsteht durch dauerhaft erhöhte Pilzzahlen, bestimmte kritische Arten und eine geschwächte Immunlage.
Wichtig:
In schimmelbelasteten Räumen solltest du dich nicht dauerhaft aufhalten. Schimmelbefall und die Ursache dahinter müssen schnellstmöglich beseitigt werden.
Wie kommt es zu einem Schimmelpilzbefall?
Schimmel braucht zum Wachsen folgende Dinge:
Sauerstoff – überall vorhanden
Sauerstoff – überall vorhanden
Sauerstoff ist in Gebäuden nahezu überall vorhanden, auch im Wandaufbau.
Temperatur – für jeden Schimmelpilz die passende Temperatur
Verschieden Schimmelpilzarten brauchen unterschiedliche Temperaturen. Daher wachsen in Innenräumen vor allem Schimmelpilze, die Raumtemperaturen um die 20°C bevorzugen. Schimmelpilze können aber ein weites Temperaturspektrum aushalten. Daher gibt es auch Schimmelpilzarten die bei 37°C Körpertemperatur wachsen können und die sind für uns Menschen besonders gefährlich.
Nahrung – organisches Material
Dazu gehören:
- Tapeten und Kleister, Gipskarton, Holzwerkstoffe, Zellulose, Papier
- Textilien, Leder, Polster
- Farben, Lacke, Kleber, Öle, Wachse und Kunststoffe mit organischen Bestandteilen
- Staub und dünne Fett- oder Schmutzschichten auf sonst „anorganischen“ Baustoffen wie Beton oder Mauerwerk.
pH-Wert – Schimmelpilze mögen es nicht alkalisch
Der pH-Wert muss auch zur jeweiligen Schimmelpilzart passen. Aber die meisten Schimmelpilzen mögen es nicht zu alkalisch. Daher werden zur Schimmelpilzsanierung und -vorbeugung gerne Kalkbaustoffe verwendet. Aber Achtung: Kalk karbonatisiert. D. h. der Kalk reagiert mit CO2 und dadurch wird die Alkalität mit der Zeit abgebaut.
Feuchtigkeit – das entscheidende Nadelöhr
Meistens sind nicht die ersten 4 Faktoren das Problem, sondern die Feuchte. Wenn genug Sauerstoff, organisches Material, der richtige pH-Wert und die optimale Temperatur vorliegt, wächst kein Schimmelpilz, wenn keine Feuchtigkeit vorhanden ist. Aber die kann auf ganz unterschiedliche Weise in dein Haus kommen oder dort „festgehalten“ werden.

Wie entsteht Feuchtigkeit in Innenräumen?
Falsches Lüftungsverhalten
Wir geben pro Tag zwischen ca. 0,5 und 6 Liter Wasser (je nach Aktivität und Temperatur) über Atmung und Schweiß an die Raumluft ab. Dazu kommen:
- Kochen,
- Duschen und Baden,
- Wäsche trocknen in der Wohnung,
- Pflanzen.
Wenn nicht ausreichend gelüftet wird, steigt die Luftfeuchtigkeit dauerhaft an. Bereits relativ unauffällige Feuchteerhöhungen können dazu führen, dass sich an kühleren Oberflächen Feuchtigkeit niederschlägt und Schimmelpilze perfekte Lebensbedingungen vorfinden.
Unsachgemäßes Heizen
Warme Luft kann mehr Wasser aufnehmen als kalte. Wird ein Raum nicht ausreichend beheizt, kühlen Oberflächen aus und die Luftfeuchte schlägt sich dort nieder. Das wird Tau- oder Kondenswasser genannt. Das heißt:
- kalte Außenwände,
- schlecht beheizte Ecken, Nischen oder wenig genutzte Räume
sind typische Problemzonen, an denen Kondenswasser entsteht und Schimmel wachsen kann.
Bauphysikalische Ursachen: Wärmebrücken, dichte Schichten & Co.
Bauliche Ursachen können sehr vielfältig sein:
- Wärmebrücken (z. B. Ecken, Deckenanschlüsse, Materialwechsel),
- falsch geplante oder ausgeführte Innendämmung,
- Baustoffe mit hohem Diffusionswiderstand, die Feuchtigkeit „einsperren“,
- fehlende oder mangelhafte Luftdichtheit, wodurch warme feuchte Raumluft in kalte Bauteile einströmt und dort kondensiert.
Oft liegt eine Kombination vor: Die Wärmedämmung ist nicht ideal, das Wohnverhalten aber auch nicht optimal. Bauphysikalische Schwächen lassen sich nur begrenzt durch perfektes Lüften kompensieren.
Bauschäden und Leckagen
Typische Feuchtequellen sind:
- undichte Badabdichtungen
- Leckagen in Wasserleitungen oder Heizungsrohren
- defekte Dachanschlüsse
- fehlende oder mangelhafte Horizontalsperre
- beschädigte Dampfbremsen, Risse im Bauteil
Schon kleine Wassermengen können ausreichen, um im Wand- oder Bodenaufbau versteckte Schimmelherde entstehen zu lassen.
Neubaufeuchte & Winterbaustelle
Bei Neubauten und Sanierungen wird sehr viel Wasser in Form von:
- Estrich
- Beton
- Mörtel, Putz
eingebracht. Bei einem massiv gebauten Einfamilienhaus können schnell 10.000 bis 40.000 Liter Wasser im Gebäude stecken, die wieder hinausmüssen.
Problematisch wird es, wenn:
- zu schnell gebaut wird,
- im Winter ohne ausreichende Beheizung und Lüftung gearbeitet wird,
- Bauteile im Bauzustand durch Regen durchnässen
- oder diffusionsdichte Schichten die Austrocknung massiv verzögern.
Das Umweltbundesamt fordert deshalb ausdrücklich, dass insbesondere bei Winterbaustellen ein detaillierter Plan für Lüftung und Beheizung während der Bauphase erstellt wird.
Wie erkenne ich einen Schimmelpilzbefall?
Manchmal ist Schimmel offensichtlich, manchmal extrem gut versteckt.
Sichtbare Anzeichen
Typische Merkmale sind:
- schwarze, grüne oder gelbliche Flecken auf Wänden, Decken, Fensterlaibungen
- flächiger oder punktförmiger Belag, oft auch mit watteartigem Flaum
- Verfärbungen an Silikon- oder Mörtelfugen, vor allem im Spritzwasserbereich im Bad
Wichtig:
Der sichtbare Schimmel ist fast immer nur die Spitze des Eisbergs. Dahinter kann der Befall im Material (z. B. hinter Tapeten, in Gipskarton, im Dämmstoff) bereits deutlich weiter fortgeschritten sein.
Versteckter Schimmel
Schimmelpilze können wachsen:
- hinter Möbeln an kalten Außenwänden
- unter Tapeten
- in abgehängten Decken
- in Hohlräumen, im Estrichaufbau oder Dachstuhl
- hinter großen Bildern, schweren Vorhängen oder in Einbauschränken
Hinweise auf versteckten Befall:
- muffiger oder modriger Geruch, der nach dem Lüften schnell wiederkommt
- dauerhaft erhöhte Luftfeuchtigkeit (Hygrometer nutzen!)
- „Mitbewohner:innen“ wie Silberfische, Staubläuse oder Hausstaubmilben, die Feuchtigkeit und Schimmel lieben
Vereinfacht kann man sagen:
lokaler Schimmelbefall deutet eher auf einen Bauschaden oder eine Wärmebrücke hin,
großflächiger Schimmel an mehreren Innen- und Außenwänden spricht eher für ein generelles Feuchtigkeits- oder Lüftungsproblem.
Fachleute und Messungen
Bei der Ursachenanalyse helfen baubiologisch geschulte Fachleute. Wichtig zu wissen:
Die Schimmelpilzart kann nicht anhand der Farbe oder mit bloßem Auge bestimmt werden – das geht nur im Labor. Und Luftmessungen auf Sporen können falsch-negativ sein, wenn der Pilz gerade in einer Phase ist, in der er kaum Sporen abgibt. Wenn du den Verdacht auf Schimmel hast, bleib hartnäckig. Ein „Da ist nichts“ reicht nicht, wenn Geruch, Feuchtewerte oder Symptome etwas anderes sagen.
Wie wird ein Schimmelpilzbefall saniert?
Eine fachgerechte Schimmelsanierung besteht immer aus drei Bausteinen:
- Ursache beseitigen: Feuchtequellen und Baufehler müssen gefunden und behoben werden.
- Primären Befall entfernen: alle Materialien, in denen Schimmel aktiv wächst (Myzel, Sporenherde).
- Sekundäre Kontamination entfernen: Sporen, Pilzfragmente, Mykotoxine und Allergene, die sich im Raum und Hausstaub verteilt haben.
Nur den sichtbaren Schimmel zu überstreichen oder mit „Zauberspray“ zu besprühen, ist technisch falsch und gesundheitlich riskant.
Wann brauchst du eine Fachfirma?
Als Faustregel gilt:
Flächen aufsummiert pro Raum unter 0,5 m², klar lokal begrenzt und ohne anhaltenden Bau- oder Feuchteschaden → kannst du mit Schutzmaßnahmen in Eigenregie bearbeiten.
Größere Flächen, unklare Ursache, wiederkehrender Befall, verdeckte Konstruktionen → unbedingt Fachfirma mit Schimmel- und Feuchteschwerpunkt hinzuziehen.
Die klassische „Lösung“, wie etwas abkratzen, Chlor drauf und Farbe drüber, ist nach aktuellem Stand der Technik nicht zulässig und wird auch von offiziellen Leitfäden ganz klar abgelehnt.
Was machen Profis bei einer Schimmelsanierung?
Je nach Schadensbild gehören dazu:
- Baustoffdiagnostik und Feuchtemessungen
- Abschottung des Bereichs (Staubschutzwände, Unterdruckgeräte)
- Arbeiten mit Schutzkleidung und Atemschutz
- Entfernen und Entsorgen befallener saugfähiger / poröser Materialien (z. B. Gipskarton, Tapeten, Spanplatten, Matratzen, Polster)
- Einsatz von Industriesaugern mit HEPA-Filter (K1- oder H-Klasse) zur Grob- und Feinreinigung der Oberflächen
- gründliches Feuchtemanagement (Trocknung, ggf. Bautrockner)
- abschließende Feinreinigung aller umliegenden Flächen und ggf. Luftreinigung
- mikrobiologische Kontrollmessungen zum Sanierungsabschluss
Essentiell ist die Beseitigung der sekundären Kontaminationen: Pilzsporen, Toxine und Allergene lagern sich überall im Staub ab, in Fugen, Ritzen, auf Möbeln, Textilien, Geräten. Werden sie nicht entfernt, bleiben gesundheitliche Beschwerden trotz „optisch saniertem“ Wandbereich oft bestehen.
Feinreinigung nach einer Schimmelsanierung
Zur Feinreinigung gehören u. a.:
- mehrmaliges Absaugen aller Oberflächen mit HEPA-Sauger (Bürsten- und Fugendüsen nutzen)
- heißes, feuchtes Wischen glatter Oberflächen mit normalem, gut fettlösenden Haushaltsreiniger
- häufiges Wechseln von Tüchern und Wischwasser
- Waschen von Gardinen, Bezügen, Decken, Kleidung mit viel Wasser, ausreichend Waschmittel und möglichst hoher Temperatur, ggf. mehrfach
- gründliches Reinigen oder Ausklopfen von Teppichen
- ggf. Entsorgung stark belasteter Polster, Matratzen und anderer poröser Gegenstände
Desinfektionsmittel sind hier nicht der Kern der Maßnahme. Ziel ist immer: Entfernen, nicht nur Abtöten.
Alkohol, Wasserstoffperoxid und warum „Schimmelsprays“ keine gute Idee sind
Wenn überhaupt desinfiziert wird, dann:
- mit Alkohol (70–80 %) oder
- mit Wasserstoffperoxid (10–30 %) auf den bereits gereinigten Oberflächen.
Beides wirkt kurzfristig, verfliegt aber rückstandsfrei und führt nicht zu einer langfristigen chemischen Raumluftbelastung. Wichtig ist:
- nur ergänzend zur mechanischen Reinigung (Saugen/Wischen),
- mit guter Lüftung,
- vorsichtig im Umgang (Explosionsgefahr bei Alkohol, Reizwirkung bei konzentriertem H₂O₂).
Von vielen im Handel angebotenen Antischimmelmitteln mit langlebigen Bioziden (z. B. quartäre Ammoniumverbindungen, Isothiazolinone, bestimmte Fungizide) ist aus baubiologischer Sicht klar abzuraten. Sie können selbst Allergien auslösen, toxisch wirken und die Raumluft belasten, ohne das eigentliche Problem (Feuchte + Pilzbiomasse) zu lösen.
Essigessenz ist für die meisten mineralischen Baustoffe (Putz, Beton, Mauerwerk) ungeeignet: Die Säure wird neutralisiert, die Wirkung lässt nach und es kann zu Schäden am Material kommen. Geeignet ist Essig eher für glatte, beschichtete Oberflächen wie Kühlschränke oder Arbeitsplatten und nicht für Putzwände.
DIY-Schimmelentfernung bei kleinen Flächen (unter 0,5 m²)
Wenn es sich um einen kleinen, lokal begrenzten Befall handelt, der nicht auf einen noch bestehenden Baufehler zurückgeht, kannst du in Eigenregie handeln. Eine mögliche Vorgehensweise (orientiert an baubiologischen Empfehlungen und dem Umweltbundesamt):
- Schutzausrüstung anziehen: mindestens Atemschutzmaske und Handschuhe.
- Lose befallene Teile und Textilien entsorgen: in dicht verschlossenen Müllsäcken.
- Poröse, stark durchwachsene Baustoffe ggf. komplett entfernen, z. B. Tapetenteile, Putzschollen.
- Schimmel feucht abwischen, nicht trocken mit feuchten Tüchern, die direkt luftdicht entsorgt werden; häufig Tuch wechseln, um keine Re-Kontamination zu verursachen.
- Oberflächen reinigen auf glatten, gut abwaschbaren Flächen mit üblichem Haushaltsreiniger und auf rauen, schwer abwaschbaren Oberflächen: ggf. Alkohol (z. B. Brennspiritus, fachgerecht verdünnt) verwenden.
- Reinigung mindestens drei Mal wiederholen mit Trocknungsphase von mindestens 30 Minuten dazwischen.
- Den gesamten Raum gründlich reinigen: Staub entfernen, saugen, wischen.
- Kleidung direkt nach der Arbeit ausziehen und heiß waschen, selbst duschen.
- Stelle offen lassen und beobachten und erst nach mehreren schimmelfreien Tagen/Wochen wieder überstreichen.
Wichtig: Wenn du unsicher bist, die Fläche größer ist oder Feuchteursachen nicht klar sind – bitte keine Experimente, sondern Fachleute holen.
Wie kann Schimmel während Sanierung und Hausbau vermieden werden?
Am besten ist es, wenn Schimmel gar nicht erst einzieht. Genau hier kannst du bei Neubau oder Sanierung viel vorbeugend tun.
Sorgfältige Planung und Ausführung
Wichtige Punkte:
- gute Wärmedämmung ohne kritische Wärmebrücken,
- Auswahl möglichst diffusionsoffener Baustoffe, damit Feuchte abtrocknen kann,
- konsequente Luftdichtheit (Blower-Door-Test nutzen),
- baubiologisch sinnvolle Details bei Anschlüssen, Durchdringungen und Übergängen.
So reduzierst du das Risiko für Kondensationsschäden und Feuchtefallen deutlich.
Bautrocknung ernst nehmen
Gerade im Neubau:
- konsequent lüften, lüften, lüften,
- während der Estrich- und Putzphase auf eine relative Luftfeuchte unter ca. 65 % achten,
- ggf. Bautrockner einsetzen,
- Räume mit nassen Estrichen temporär von anderen Bereichen abtrennen,
- Trockenbauweisen bevorzugen, um unnötigen Feuchteeintrag zu vermeiden.
Bei Winterbaustellen sollten Bauteile abgedeckt, Gebäude beheizt und systematisch gelüftet werden. Ohne Konzept steigt das Risiko, dass „die Schimmelpilze einziehen, bevor du einziehst“.
Sanierung: bestehende Fehler mitdenken
Bei der Sanierung gilt ebenfalls:
- Planungsfehler und Ausführungsfehler aus der Vergangenheit erkennen und beheben,
- Luftdichtheitsebene / Dampfbremse nicht beschädigen oder fachgerecht wieder schließen,
- möglichst trockene Bauweisen und Baustoffe einsetzen.
Auch hier gilt: Jede unnötige Feuchte im Bestand erhöht das Risiko für Schimmel – besonders in kritischen Details.

Welchen Einfluss hat das Wohnverhalten auf die Entstehung von Schimmel?
Selbst bei einem gut geplanten Gebäude kann dein Wohnverhalten den Unterschied machen.
Richtig lüften
- Keine Dauer-Kippstellung der Fenster.
- Lieber mehrmals am Tag stoßlüften (weit geöffnete Fenster, kurz und intensiv).
- Querlüftung (Durchzug) ist besonders effektiv.
- Lüftungsanlagen können ein sinnvolles Werkzeug sein, ersetzen aber nicht das Verständnis für Feuchte und Raumklima.
Feuchteeintrag reduzieren
- Wäsche möglichst nicht in Wohnräumen trocknen.
- Beim Kochen Dunstabzugshaube benutzen.
- Nach dem Duschen/Baden: zuerst nach außen lüften, nicht in den Flur.
- Bei hoher Feuchte: Hygrometer nutzen und Werte im Blick behalten.
Ausreichend heizen – Oberflächentemperaturen im Blick
- Räume nicht zu stark auskühlen lassen
- Insbesondere Problemstellen (Ecken, Außenwände, schlecht gedämmte Bereiche) im Auge behalten.
- Zu kalte Oberflächen → Kondensat → Schimmelrisiko.
Möbel richtig stellen
- Möbel mit Abstand an Außenwände, besonders in ungedämmten Gebäuden
- keine „tapetenbreiten“ Schrankwände direkt an kalten Außenwänden
- große Bilder, luftdichte Tapeten und schwere Vorhänge können die Wand „dämmen“ und dahinter Tauwasser begünstigen.
Wasserschäden ernst nehmen
- Bei einem Wasserschaden zählt jeder Tag
- sofort reagieren, Ursachen beheben, Bautrockner einsetzen
- betroffene Bereiche prüfen (auch in Hohlräumen und Aufbauten)
Wichtig: Schimmel ernst nehmen – aber nicht hilflos sein
Schimmel in der Wohnung ist immer ein Warnsignal: für zu viel Feuchtigkeit, bauliche Schwächen oder ein überfordertes Raumklima. Gleichzeitig ist Schimmel ein komplexes Thema, bei dem es selten reicht, nur „die Flecken“ zu entfernen.
Wichtig ist:
- Ursache finden und beheben,
- Befallene Materialien entfernen,
- Sporen und Pilzbestandteile gründlich aus der Umgebung reinigen,
- dein Wohnverhalten so anpassen, dass Feuchtigkeit gar nicht erst zum Problem wird.
Wenn du unsicher bist, ob es sich bei dir um einen Bagatellschaden oder ein größeres Problem handelt, oder wenn du gesundheitliche Beschwerden in Verbindung mit deinem Wohnumfeld vermutest, hol dir Unterstützung.
Als Baubiologin und baubiologische Messtechnikerin helfe ich dir dabei, Schimmelursachen aufzuspüren, die Belastung einzuschätzen und sinnvolle Sanierungswege zu finden, damit dein Zuhause wieder gesund wird und es auch bleibt.